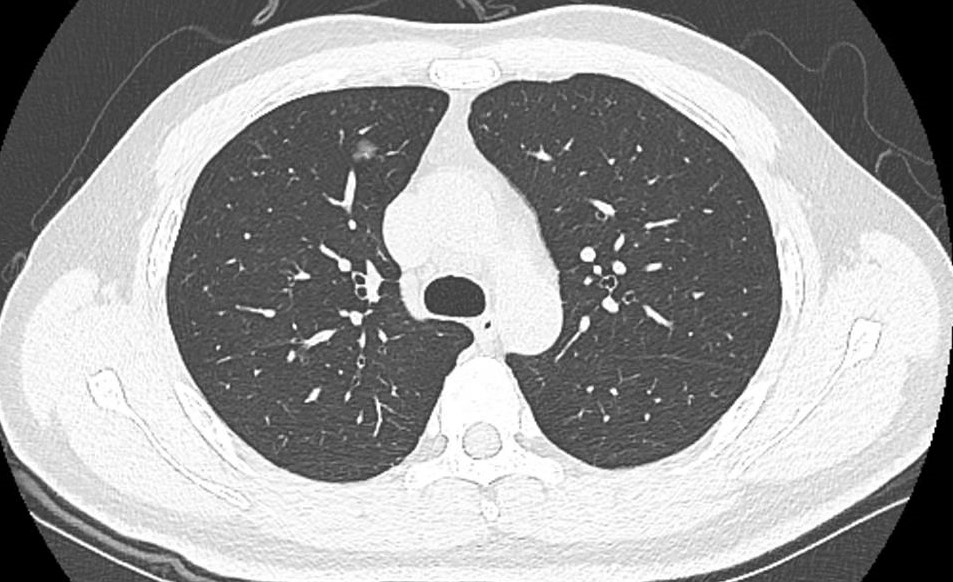

谢先生最近遇到了一些烦心事,6年前谢先生因为发现慢性肾功能不全,一直规律口服药物治疗。今年10月,谢先生在苏州市独墅湖医院(苏州大学附属独墅湖医院)住院期间,复查胸部CT时发现右肺上叶生长了一个肺磨玻璃结节,谢先生非常焦急担忧,肾内科乔青主任了解谢先生的情况,建议他来我院的肺结节多学科会诊(MDT)门诊就诊。
针对临床上各类肺结节诊疗问题,独墅湖医院特别安排了肺结节多学科会诊(MDT)门诊,解决广大患者就医问题,门诊由呼吸科与危重症医学科蒋军红主任、胸心大血管外科马海涛主任、放射科郭亮主任、介入与血管外科程龙副主任医师等知名专家联合坐诊。针对谢先生的情况,专家们共同查阅了谢先生的CT图像,其结节周围有分刺征象,CT表现倾向于早期肺癌,考虑微浸润癌向浸润癌进展,且谢先生目前十分年轻,建议早日治疗。但是谢先生有慢性肾脏病病史,高血压控制不佳,考虑谢先生传统手术风险高,建议谢先生行CT引导下活检+微波消融手术。
微波消融术是近年来发展起来的微创、安全、有效的肿瘤原位灭活新技术,是在CT引导下经过皮肤直接穿刺肿块,将微波消融针精确穿刺到肿块,消融针针尖部发射微波,在针尖周围形成高热场,使肿瘤细胞坏死,达到杀灭肿瘤的目的。该手术具有创伤小、安全、治疗时间短、术后恢复快、整体治疗费用降低、重复性高、仅需要局部麻醉就可以实施等优势,非常适合谢先生此类情况。听了专家的介绍,谢先生放心了许多,选择了接受微波消融治疗。
11月9日,在蒋军红主任的指导下,程龙医师操刀,在CT的精准定位下,精准穿刺至肺结节中心部位,取完活检后精准消融,消融完全后复查CT结节周围被完全包绕,治疗效果满意。手术时间持续约45分钟,谢先生几乎没有感受到任何疼痛。术后,谢先生没有感受到不适,第二天就可以下床活动,目前已经顺利出院。结节的穿刺组织中也发现了异型细胞(考虑恶性肿瘤),谢先生表示非常感谢独墅湖医院肺结节MDT门诊和介入与血管外科医护人员,帮他解决了大难题。此次诊疗过程这充分体现了我院肺小结节MDT的个性化治疗和综合实力。
据程龙医生介绍,肺结节微波消融适应于周围型磨玻璃影(GGN)患者,对于不能耐受手术、拒绝手术切除治疗,多次手术后及多发磨玻璃结节患者都是很好的选择,同时也是肺磨玻璃结节的综合治疗的重要组成部分。
(箭头所指出:术前右肺上叶磨玻璃结节,周围可见分刺征)

(箭头所指处:结节消融完全,周围被包绕,未见明显出血及气胸征象)
科普时间:
近年来,随着低剂量螺旋计算机断层扫描(low-dose computed tomography LDCT)筛查项目的广泛开展,越来越多的无症状肺结节被发现。肺结节在我国检出率为20%-80%,LDCT筛查97%以上的肺部结节为良性病变,肺癌的检出率仅为0.7%-2.3%。微波消融术作为一种精准的微创技术已经应用于早期肺癌的治疗,全国范围内每年的治疗例数迅速增加,该技术具有创伤小、疗效明确、安全性高、可重复性强、适应人群广等特点。
1.什么是微波消融术?
微波消融属于微创治疗方法,其原理在微波电磁场的作用下,肿瘤组织内的水分子,蛋白质分子产生高速振动,造成分子之间的相互碰撞、摩擦,在短时间内产生高达60-150摄氏度的高温,导致细胞凝固性坏死,说简单一点,就是肿瘤被烧死了。
2.肺结节微波消融术适应人群?
周围型磨玻璃影(GGN)患者(病灶<30mm、毛刺征、分叶征、胸膜凹陷、空泡征、血管集束征、动态观察GGN增大、出现实性成分或实性成分增加):(1)因心肺功能差或高龄不能耐受手术切除;(2)拒绝行手术切除;(3)外科切除后又新出现的病灶或遗留病灶,患者无法耐受再次手术或拒绝再次手术;(4)多发磨玻璃影(先消融主病灶,其他病灶根据发展情况考虑再次消融);(5)各种原因导致的重度胸膜粘连或胸膜腔闭锁;(6)单肺(各种原因导致一侧肺缺如);(7)重度焦虑,经心理或药物治疗无法缓解。
3.禁忌症
(1)血小板<50x109/L;(2)有严重出血倾向、短期内不能纠正的凝血功能障碍(凝血酶原时间>18s,凝血酶原活动度<40%);(3)严重的肺纤维化和肺动脉高压;(4)抗凝治疗和/或抗血小板药物在消融前停用未超过5d-7d。

消融针及微波治疗仪(图片来源于网络)